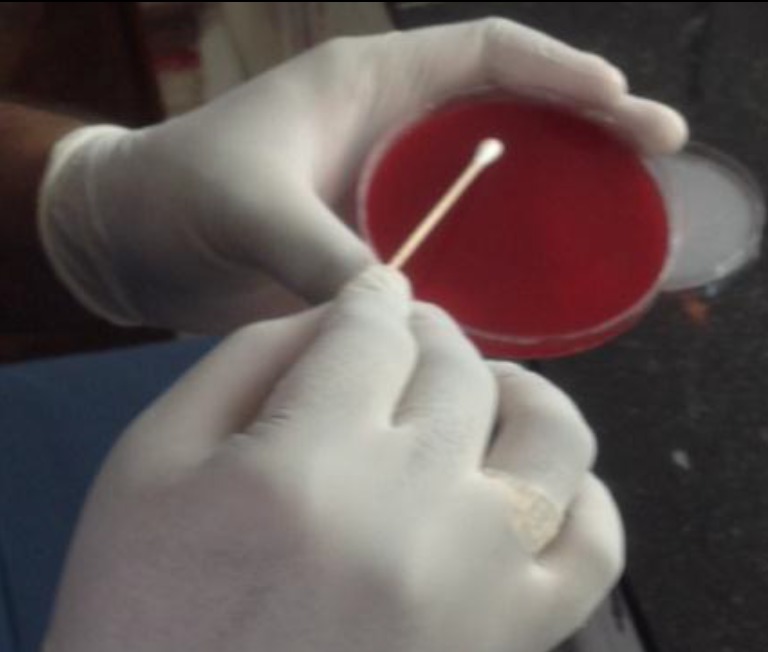
2959324_File000001.jpg

IADR Abstract Archives
Comparative Evaluation Of Bacterial Count in Root Canal After Different Instrumentation Techniques
Objectives:
The Objective of the study is to
1. To Evaluate the bacterial count in root canal after instrumentation with hand , continuous and reciprocating system,
2. To compare the efficacy of hand file with continuous rotary file in removing bacteria from root canal.
3. To compare the efficacy of hand file with reciprocating file in removing bacteria from root canal.
4. To compare the efficacy of continuous rotary file with reciprocating file in removing bacteria from root canal.
Methods: In a prospective randomized clinical trial, 72 patients were selected with mean age between 18 to 70 years according to inclusion and exclusion criteria and base line score was recorded. Based on block randomisation patients were divided in to Group I Hand file (n=24), Group II Rotary Protaper Universal (n=24) and Group III Reciprocating WaveOne Gold (n=24). Routine root canal preparation, in group I, group II, group III using respective instruments were done and irrigated using endodontic needle inside the canal 2mm short of apex. Pre-operative and post-instrumentation samples were taken using paper point. Anaerobic culture has been done and number of colony forming units were counted and antibacterial efficacy was statistically analysed.
Results:
All the three tested instrumentation technique showed reduction in bacterial growth. There was a statistical significant difference between hand and rotary protaper universal and reciprocating waveone gold. But no statistical significant difference between rotary protaper universal and reciprocating waveone gold was noticed.
Conclusions:
Within the limitations of this study, it was concluded that there was statistical significant difference between the hand and other instrumentation technique used. No significant difference was found between rotatory protaper universal and reciprocating waveone gold.
The Objective of the study is to
1. To Evaluate the bacterial count in root canal after instrumentation with hand , continuous and reciprocating system,
2. To compare the efficacy of hand file with continuous rotary file in removing bacteria from root canal.
3. To compare the efficacy of hand file with reciprocating file in removing bacteria from root canal.
4. To compare the efficacy of continuous rotary file with reciprocating file in removing bacteria from root canal.
Methods: In a prospective randomized clinical trial, 72 patients were selected with mean age between 18 to 70 years according to inclusion and exclusion criteria and base line score was recorded. Based on block randomisation patients were divided in to Group I Hand file (n=24), Group II Rotary Protaper Universal (n=24) and Group III Reciprocating WaveOne Gold (n=24). Routine root canal preparation, in group I, group II, group III using respective instruments were done and irrigated using endodontic needle inside the canal 2mm short of apex. Pre-operative and post-instrumentation samples were taken using paper point. Anaerobic culture has been done and number of colony forming units were counted and antibacterial efficacy was statistically analysed.
Results:
All the three tested instrumentation technique showed reduction in bacterial growth. There was a statistical significant difference between hand and rotary protaper universal and reciprocating waveone gold. But no statistical significant difference between rotary protaper universal and reciprocating waveone gold was noticed.
Conclusions:
Within the limitations of this study, it was concluded that there was statistical significant difference between the hand and other instrumentation technique used. No significant difference was found between rotatory protaper universal and reciprocating waveone gold.